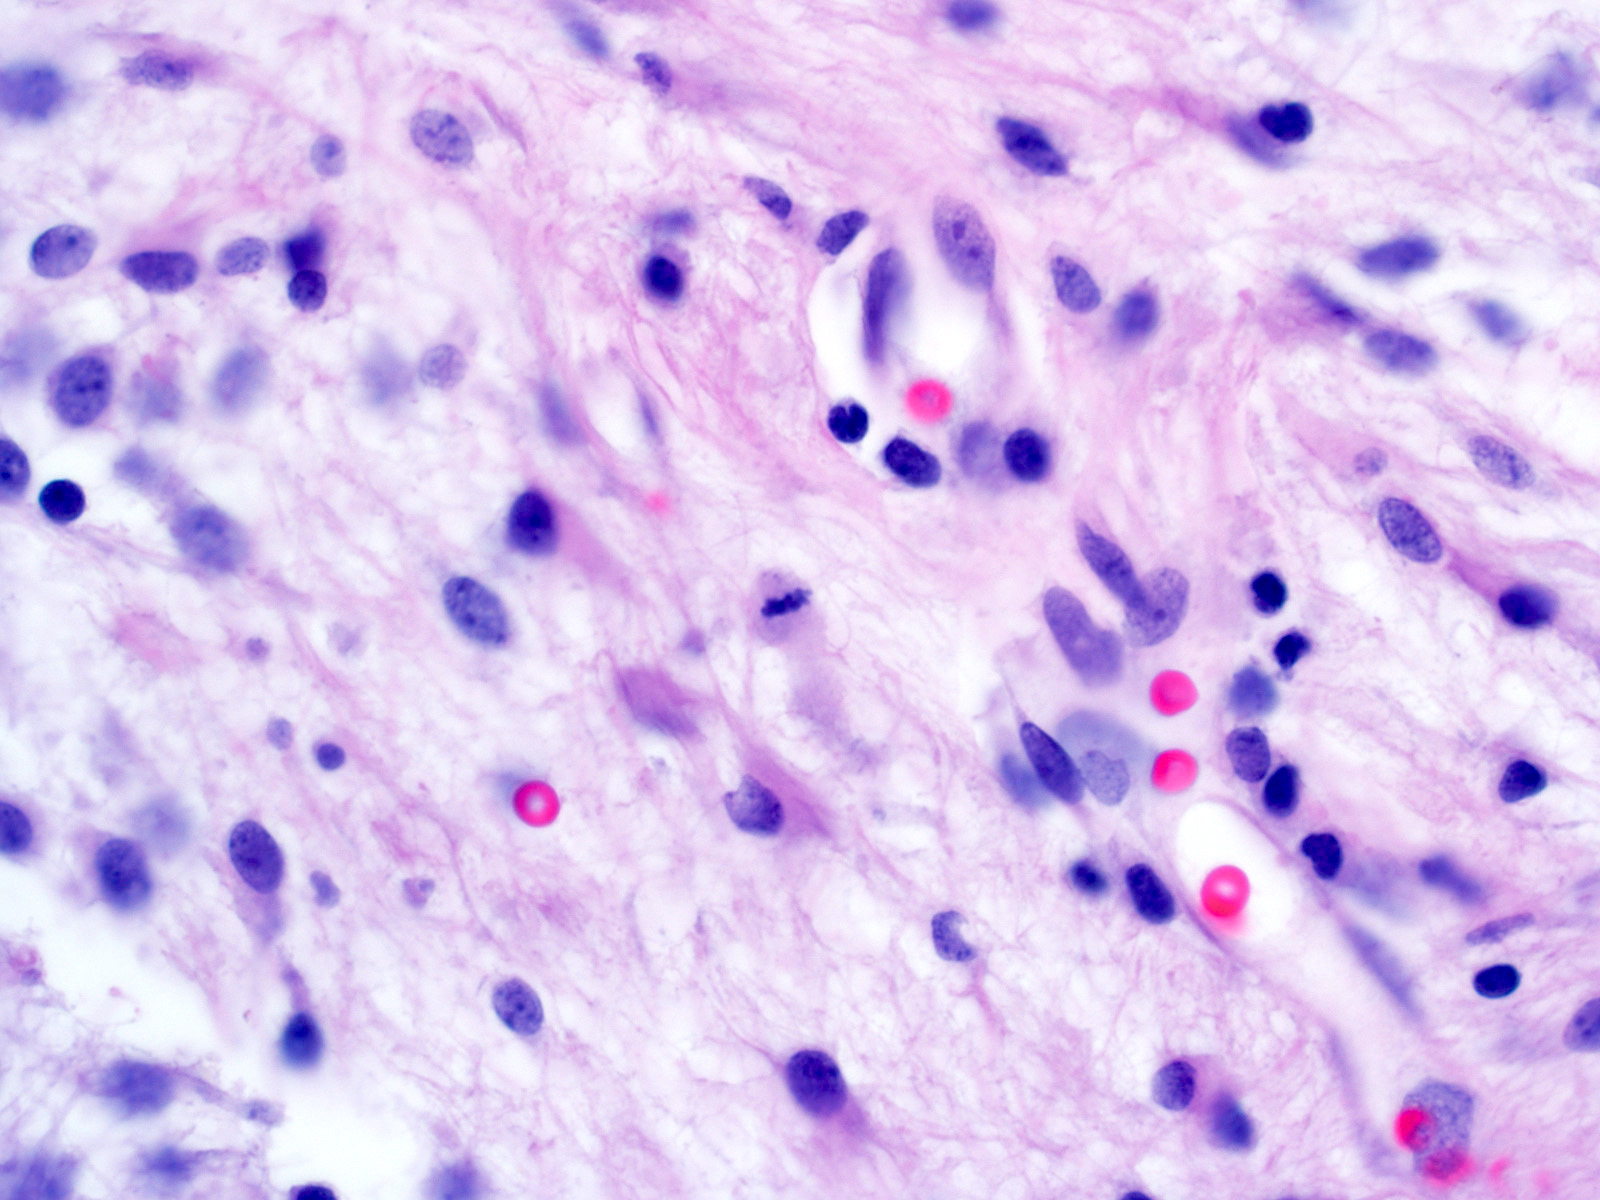

Table of Contents
Definition / general | Essential features | Terminology | ICD coding | Epidemiology | Sites | Pathophysiology | Etiology | Diagrams / tables | Clinical features | Diagnosis | Radiology description | Radiology images | Prognostic factors | Case reports | Treatment | Clinical images | Gross description | Gross images | Intraoperative frozen / smear cytology images | Microscopic (histologic) description | Microscopic (histologic) images | Virtual slides | Cytology description | Positive stains | Negative stains | Electron microscopy description | Electron microscopy images | Molecular / cytogenetics description | Molecular / cytogenetics images | Videos | Sample pathology report | Differential diagnosis | Additional references | Board review style question #1 | Board review style answer #1 | Board review style question #2 | Board review style answer #2Cite this page: Yoda R, Cimino PJ. Pilocytic astrocytoma. PathologyOutlines.com website. https://www.pathologyoutlines.com/topic/cnstumorpilocyticastrocytoma.html. Accessed April 24th, 2024.
Definition / general
- Circumscribed, well differentiated astrocytic neoplasm with piloid (hair-like) processes, most commonly occurring in children and young adults, WHO grade 1 (Acta Neuropathol 2016;131:803)
Essential features
- Most common glioma in children (Neuro Oncol 2020;22:iv1)
- Radiologic appearance often cystic with an enhancing mural nodule (Radiographics 2004;24:1693)
- Generally circumscribed, biphasic, astrocytic neoplasm with piloid processes, Rosenthal fibers and eosinophilic granular bodies (EGBs)
- Activating genetic alterations in components of MAPK pathway (most frequently BRAF fusions) (Nat Genet 2013;45:927, Nat Genet 2013;45:602)
- WHO grade 1 (Acta Neuropathol 2016;131:803)
Terminology
- Pilocytic astrocytoma
- Juvenile pilocytic astrocytoma (not recommended)
- Spongioblastoma (not recommended)
- Pilomyxoid astrocytoma (subtype)
- Optic nerve glioma
ICD coding
Epidemiology
- M = F (Neuro Oncol 2014;16:iv1)
- 5.4% of all gliomas (J Neuropathol Exp Neurol 2005;64:479)
- Most common glioma in children (Neuro Oncol 2014;16:iv1)
- Most common glioma during first 2 decades of life (Neuro Oncol 2014;16:iv1)
Sites
- Found throughout neuraxis
- Most common sites: cerebellum (42%), supratentorial (36%), optic pathway / hypothalamus (9%), brainstem (9%), spinal cord (2%) (J Neurosurg 2003;98:1170)
- Infratentorial location most common in childhood (J Neurooncol 2017;131:163)
Pathophysiology
- Mutation in MAPK pathway component → pathway activation → transcription factor activation → increased cell growth and proliferation
- Biallelic inactivation of NF1 in the setting of neurofibromatosis type 1 (Genome Res 2013;23:431)
Etiology
- Most cases are sporadic
- Germline mutations in MAPK pathway genes, including FGFR1, NF1, PTPN11 and RAF1
Clinical features
- Neurological deficits depending on tumor location
- Nonlocalizing signs
- Macrocephaly
- Headache
- Endocrinopathy
- Increased intracranial pressure
- Optic pathway tumors in 15% of patients with neurofibromatosis type 1 (Ophthalmology 1984;91:929)
Diagnosis
- Diagnosis may be made on histologic features alone (Acta Neuropathol 2015;129:775)
- When microscopic findings are limited / ambiguous, molecular testing may be necessary to assess for gene fusions and other alterations
Radiology description
- Well demarcated enhancing mass (Insights Imaging 2014;5:387)
- Cystic mass with enhancing mural nodule (~66% of cases), solid or heterogeneous mixed solid - cystic
- Fusiform mass in optic pathway
Prognostic factors
- 10 year survival > 95% after surgical intervention alone (J Neurosurg 2003;98:1170)
- Optic nerve tumors in NF1 patients: favorable (Ann Neurol 2007;61:189)
- Deep, midline location: high rates of incomplete resection, recurrence, shorter survival (Neuropathol Appl Neurobiol 2013;39:693)
- Supratentorial: poor (Cancer 1993;72:1335)
- Partial resection: poor (Neurosurgery 2003;53:544)
- Age > 40: poor (J Neurooncol 2020;148:187)
- Anaplastic features in adults: poor, no definitive WHO grade (Am J Surg Pathol 2010;34:147, Acta Neuropathol 2020;139:287, Acta Neuropathol 2016;131:803)
- Pilomyxoid astrocytoma variant: unclear prognosis, no definitive WHO grade (Acta Neuropathol 2016;131:803)
Case reports
- 13 year old girl with left cerebellar cystic mass (NMC Case Rep J 2019;6:95)
- 33 year old woman with mesial temporal lobe mass (Case Rep Pathol 2020;2020:5903863)
- 39 year old woman with optic nerve glioma (Brain Tumor Pathol 2021;38:59)
Treatment
- Gross total surgical resection
- Radiation or chemotherapy may be considered for subtotally resected or recurrent cases
- Variable success reported for MAPK pathway targeted therapies (Proc Natl Acad Sci U S A 2013;110:5957, Nat Med 2013;19:1401)
Clinical images
Gross description
- Usually well circumscribed (Acta Neuropathol 2015;129:775)
- Commonly cystic
- May have myxoid or mucoid appearance
- May contain calcifications or hemosiderin staining
Intraoperative frozen / smear cytology images
Microscopic (histologic) description
- Growth pattern
- Predominantly solid / circumscribed; often limited peripheral infiltration
- Frequent extension into subarachnoid space
- Biphasic appearance
- Compact fibrillar portions: elongated nuclei, bipolar piloid processes, Rosenthal fibers
- Loose microcystic portions: round to oval nuclei, cobweb-like processes, eosinophilic granular bodies
- Occasional "pennies on a plate" multinucleated cells
- Oligodendroglioma-like areas may be present
- Glomeruloid vessels
- Regressive / degenerative changes
- Degenerative atypia
- Vascular hyalinization
- Infarct-like necrosis
- Calcification
- Perivascular lymphocytes
- Anaplasia in a minority of cases
- Increased mitotic activity (> 4 mitoses/10 high power fields) with or without necrosis (Am J Surg Pathol 2010;34:147)
- Pilomyxoid astrocytoma subtype
- Variant with angiocentric arrangement of monophasic bipolar tumor cells in a myxoid background
Microscopic (histologic) images
Contributed by P.J. Cimino, M.D., Ph.D.
Cytology description
- Smear preparation (alcohol fixed, H&E stained) (Cancer Cytopathol 2015;123:331)
- Mildly atypical glial cells with long piloid processes
- Ovoid nuclei with delicate chromatin
- Rosenthal fibers
- Eosinophilic granular bodies
Positive stains
- Tumor cells:
- GFAP (Am J Surg Pathol 2012;36:43)
- Olig2 (J Neurooncol 2011;104:423)
- S100 (Am J Surg Pathol 2012;36:43)
- SOX10 (J Neuropathol Exp Neurol 2016;75:295)
- ATRX (retained nuclear staining) (Surg Neurol Int 2018;9:29, Acta Neuropathol 2020;139:287)
- Ki67 (generally low but increased with anaplasia) (J Neuropathol Exp Neurol 1999;58:46, Hum Pathol 1998;29:1511, J Clin Oncol 2003;21:2968, Am J Surg Pathol 2010;34:147)
- Eosinophilic granular bodies (EGBs) (Hum Pathol 1998;29:1511):
- Rosenthal fibers (Hum Pathol 1998;29:1511, Acta Neuropathol 1985;66:155):
Negative stains
- IDH1 R132H (Brain Pathol 2010;20:245)
- p53 (weak / low to absent) (Histopathology 1998;33:446)
- BRAF V600E (~5% of cases) (Brain Behav 2017;7:e00641)
Electron microscopy description
- Rosenthal fibers: amorphous, electron dense elements surrounded by intermediate filaments within astrocytic processes (J Pathol Transl Med 2015;49:427)
- Eosinophilic granular bodies: round body, electron dense homogeneous material
Molecular / cytogenetics description
- Activating alterations in components of MAPK pathway (Nat Genet 2013;45:927, Nat Genet 2013;45:602)
- > 70% KIAA1549-BRAF fusion due to 7q34 tandem duplication
- ~90% cerebellar cases
- ~50% supratentorial cases
- ~5% other BRAF fusion
- ~5% BRAF V600E
- ~8% NF1 loss
- < 5% FGFR1 mutation
- < 5% FGFR1 fusions / internal tandem duplication
- ~2% NTRK fusions
- PTPN1 mutation (rare)
- KRAS mutation (rare)
- RAF1 fusions (rare)
- > 70% KIAA1549-BRAF fusion due to 7q34 tandem duplication
- Chromosomal polysomies (5, 6, 7, 11, 15) detected by comparative genomic hybridization (CGH) (J Neuropathol Exp Neurol 2006;65:1049, Br J Cancer 2000;82:1218)
- Infratentorial / supratentorial tumors show distinct gene expression and DNA methylation signatures (Acta Neuropathol 2013;126:291)
- H3 K27M mutation (rare) (Brain Pathol 2019;29:126)
- Negative for IDH1 / IDH2 exon 4 mutations
- Usually negative for TP53 mutations
Molecular / cytogenetics images
Videos
Pilocytic astrocytoma
Rosenthal fibers in pilocytic astrocytoma
Sample pathology report
- Brain, cerebellum, biopsy:
- Pilocytic astrocytoma, WHO grade 1 (see comment)
- Comment: Positive for KIAA1549-BRAF fusion.
Differential diagnosis
- Neoplastic
- Diffuse glioma (including oligodendroglioma, IDH mutant astrocytoma, IDH wildtype astrocytic gliomas, diffuse midline glioma, H3 K27M mutant):
- Diffusely infiltrative
- Eosinophilic granular bodies and Rosenthal fibers uncommon
- Distinct molecular features
- High grade astrocytoma with piloid features:
- High grade histological features
- Distinct molecular features
- Frequent loss of ATRX nuclear staining (Acta Neuropathol 2018;136:273)
- Diffuse leptomeningeal glioneuronal tumor:
- Primary leptomeningeal location
- Commonly not reactive for GFAP
- Distinct molecular features
- Pleomorphic xanthoastrocytoma:
- Most frequently in superficial cerebral cortex
- Pleomorphic, occasionally xanthomatous cells
- Reticulin rich foci
- Ganglioglioma:
- Neoplastic dysmorphic ganglion cells
- Dysembryoplastic neuroepithelial tumor:
- Predominantly cortical
- Mucin rich nodules
- Floating neurons in microcysts
- Diffuse glioma (including oligodendroglioma, IDH mutant astrocytoma, IDH wildtype astrocytic gliomas, diffuse midline glioma, H3 K27M mutant):
- Nonneoplastic
- Reactive piloid gliosis:
- Hypocellular
- Lack of genetic alterations
- Vascular malformation
- Reactive piloid gliosis:
Additional references
Board review style question #1
Board review style answer #1
D. BRAF fusion involving KIAA1549. TP53 mutations (answer A) are uncommon in pilocytic astrocytoma. IDH1 R132H (answer B) is the most common mutation in IDH mutant astrocytomas and oligodendrogliomas but should be negative in pilocytic astrocytomas. BRAF V600E mutation (answer C) and NF1 loss (answer E) occur in pilocytic astrocytomas at lower frequencies.
Comment Here
Reference: Pilocytic astrocytoma
Comment Here
Reference: Pilocytic astrocytoma
Board review style question #2
Which of the following is true of pilocytic astrocytomas?
- Show diffuse p53 immunoreactivity
- Most frequently occur in adults
- Demonstrate reticulin rich foci
- Associated with neurofibromatosis 2
- Potentially curable with resection
Board review style answer #2
E. Potentially curable with resection. Pilocytic astrocytomas should not show significant p53 immunopositivity (answer A) and they usually occur in children (answer B). Reticulin rich foci are a more typical feature of pleomorphic xanthoastrocytoma or gliosarcoma (answer C). In addition, pilocytic astrocytomas are associated with NF1 (answer D).
Comment Here
Reference: Pilocytic astrocytoma
Comment Here
Reference: Pilocytic astrocytoma